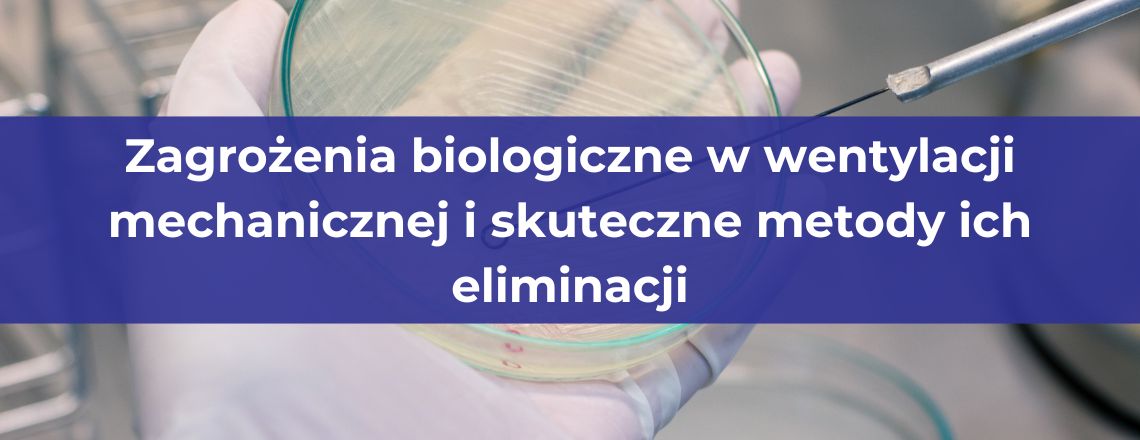

Blog
Wszystko, co chcesz wiedzieć o wentylacji i klimatyzacji
Najnowsze wpisy
Platformy wiertnicze to wyjątkowe środowiska pracy, które wymagają nie tylko specjalistycznej wiedzy technicznej, ale również dbałości o bezpieczeństwo i higienę pracy. Jednym z kluczowych elementów zapewniających odpowiednie warunki na takich obiektach jest system wentylacji. Regularne czyszczenie wentylacji na platformach wiertniczych w połączeniu z dezynfekcją są niezbędne, aby utrzymać jakość powietrza, zmniejszyć ryzyko pożarowe i zapewnić
Czytaj więcej...Wypełnij formularz – oddzwonimy!
Zastanawiasz się nad czyszczeniem wentylacji? Chcesz poznać koszt dla Twojego budynku? Kliknij i wypełnij formularz, a my oddzwonimy do Ciebie i przedstawimy cały plan działania. Z nami to będzie naprawdę proste!
Pozostałe wpisy
Właściwa jakość powietrza w szkołach i przedszkolach ma kluczowe znaczenie dla zdrowia dzieci i kadry pedagogicznej. Układy wentylacyjne, które nie są regularnie czyszczone, mogą gromadzić kurz, alergeny, bakterie i pleśń.
Czytaj więcej...Czyszczenie wentylacji to temat, który wciąż budzi wiele emocji i kontrowersji. W przestrzeni publicznej funkcjonuje mnóstwo mitów na temat konieczności i skuteczności tej usługi. Warto oddzielić fakty od fałszywych przekonań,
Czytaj więcej...Powietrze, którym oddychamy na co dzień, ma bezpośredni wpływ na nasze zdrowie i samopoczucie. W przypadku kobiet w ciąży staje się to jeszcze bardziej istotne – zarówno dla organizmu matki,
Czytaj więcej...Tekstylne rękawy wentylacyjne to nowoczesne rozwiązanie stosowane w systemach wentylacyjnych wielu obiektów – od hal produkcyjnych, przez magazyny, po obiekty użyteczności publicznej. Ich zadaniem jest nie tylko równomierne rozprowadzanie powietrza,
Czytaj więcej...Systemy wentylacyjne to kluczowy element każdej nowoczesnej inwestycji budowlanej – zarówno w sektorze mieszkaniowym, jak i przemysłowym. Odpowiednio dobrana wentylacja zapewnia właściwą jakość powietrza wewnątrz pomieszczeń, reguluje poziom wilgoci oraz
Czytaj więcej...Sprawnie działający system wentylacyjny to nie tylko komfort, ale przede wszystkim zdrowie domowników i wysoka efektywność energetyczna budynku. Serce każdego systemu wentylacji mechanicznej stanowią filtry powietrza, które odpowiadają za zatrzymywanie
Czytaj więcej...Sprawna wentylacja przemysłowa to nie tylko kwestia komfortu pracy, ale przede wszystkim gwarancja ciągłości produkcji, bezpieczeństwa pracowników i zgodności z przepisami BHP. Zanieczyszczone kanały wentylacyjne mogą prowadzić do poważnych zakłóceń
Czytaj więcej...Wentylacja biurowa to jeden z najważniejszych, choć często niedocenianych elementów zdrowego środowiska pracy. W dobie rosnącej świadomości na temat jakości powietrza i jego wpływu na zdrowie, odpowiednie funkcjonowanie systemu wentylacyjnego
Czytaj więcej...Wentylacja w kuchni gastronomicznej odgrywa istotną rolę nie tylko w zapewnieniu komfortu pracy i jakości powietrza, ale także w kontekście bezpieczeństwa przeciwpożarowego. Systemy wentylacyjne, w których regularnie przygotowuje się jedzenie,
Czytaj więcej...Systemy wentylacyjne to układ oddechowy każdego budynku – niezależnie od tego, czy mowa o przestrzeniach mieszkalnych, biurowych, czy przemysłowych. Zaniedbane kanały wentylacyjne mogą prowadzić do poważnych zagrożeń: od rozwoju pleśni
Czytaj więcej...W lokalach gastronomicznych wentylacja odgrywa kluczową rolę w zapewnieniu bezpiecznych i higienicznych warunków pracy. W systemach wyciągowych kuchni gromadzą się tłuszcze, para wodna i inne zanieczyszczenia, które mogą prowadzić do
Czytaj więcej...Wentylacja w lokalu gastronomicznym to znacznie więcej niż tylko montaż okapu nad kuchenką. Choć okap stanowi ważny element systemu wentylacyjnego, jego obecność nie gwarantuje skutecznej wymiany powietrza ani bezpieczeństwa sanitarnego
Czytaj więcej...System wentylacji mechanicznej to jeden z kluczowych elementów każdego nowoczesnego budynku – odpowiada nie tylko za komfort cieplny i jakość powietrza, ale również za zużycie energii. W dobie rosnących cen
Czytaj więcej...Wentylacja mechaniczna odgrywa kluczową rolę w zapewnieniu odpowiedniej jakości powietrza wewnątrz budynków – zarówno mieszkalnych, jak i przemysłowych czy biurowych. Niestety, nieodpowiednio konserwowane systemy wentylacyjne mogą stać się siedliskiem niebezpiecznych
Czytaj więcej...Wentylacja mechaniczna to jeden z najskuteczniejszych sposobów zapewnienia świeżego powietrza w nowoczesnych budynkach – zarówno mieszkalnych, jak i komercyjnych. Dzięki niej możliwe jest kontrolowanie przepływu powietrza, odzyskiwanie ciepła (rekuperacja), a
Czytaj więcej...Większość z nas spędza nawet 90% czasu w zamkniętych pomieszczeniach – w domu, w pracy, w szkole. Właśnie dlatego jakość powietrza wewnętrznego ma ogromne znaczenie dla naszego zdrowia, samopoczucia i
Czytaj więcej...System rekuperacji to nowoczesne rozwiązanie, które zapewnia stałą wymianę powietrza w domu, jednocześnie odzyskując ciepło z powietrza wywiewanego. Jednak by jego działanie było skuteczne i bezpieczne, niezbędna jest jego regularna
Czytaj więcej...Wiosna to czas odświeżenia – zarówno dla przyrody, jak i dla naszych domów. Jednym z kluczowych elementów, o który warto zadbać w tym okresie, jest system rekuperacji, czyli wentylacja mechaniczna
Czytaj więcej...Filtry HEPA stanowią fundament skutecznej filtracji powietrza w pomieszczeniach o kontrolowanej czystości – od laboratoriów po sale operacyjne. Aby jednak mieć pewność, że działają zgodnie z założeniami, niezbędne jest regularne
Czytaj więcej...Wentylacja mechaniczna odgrywa kluczową rolę w zapewnianiu odpowiedniej jakości powietrza wewnątrz budynków. Choć jej zadaniem jest usuwanie zanieczyszczeń i dostarczanie świeżego powietrza, sama może stać się źródłem poważnych zagrożeń mikrobiologicznych.
Czytaj więcej...Nieprzyjemne zapachy w lokalach gastronomicznych to nie tylko dyskomfort dla klientów i personelu, ale też poważne zagrożenie dla reputacji miejsca. W branży, gdzie wrażenia zapachowe odgrywają kluczową rolę w odbiorze
Czytaj więcej...Czysta i sprawna wentylacja to podstawa zdrowego mikroklimatu wewnątrz budynków – zarówno mieszkalnych, jak i przemysłowych. Zimą, kiedy większość czasu spędzamy w zamkniętych pomieszczeniach i rzadziej otwieramy okna, jakość powietrza
Czytaj więcej...Jakość powietrza ma bezpośredni wpływ na zdrowie ludzi oraz funkcjonowanie urządzeń technicznych w pomieszczeniach. Zanieczyszczenia powietrza — zwłaszcza mikrobiologiczne — mogą prowadzić do poważnych problemów zdrowotnych i obniżać jakość życia.
Czytaj więcej...Utrzymanie czystości w systemach wentylacyjnych, w tym tekstylnych rękawów, to nie tylko kwestia estetyki, ale przede wszystkim higieny i wydajności całego systemu. Brak regularnego czyszczenia kanałów może prowadzić do pogorszenia
Czytaj więcej...Regularne czyszczenie kanałów wentylacyjnych to kluczowy element dbania o jakość powietrza w budynkach oraz sprawność całego systemu wentylacyjnego. Zanieczyszczone przewody wpływają nie tylko na komfort użytkowników, ale także na wyższe
Czytaj więcej...Filtry HEPA są nieodzownym elementem systemów wentylacyjnych w pomieszczeniach czystych, laboratoriach, szpitalach i zakładach farmaceutycznych. Aby ich skuteczność była zgodna z najwyższymi normami, niezbędna jest regularna walidacja filtrów HEPA –
Czytaj więcej...Utrzymanie czystości w lokalach gastronomicznych to nie tylko kwestia estetyki, ale przede wszystkim obowiązek wynikający z przepisów sanitarnych i zasad bezpieczeństwa. Jednym z kluczowych obszarów, o który należy zadbać, są
Czytaj więcej...Drukarki i kserokopiarki to nieodłączne elementy biurowego środowiska pracy. Korzystamy z nich codziennie, często nie zastanawiając się, czy mogą mieć jakikolwiek wpływ na nasze zdrowie. Czy emisja szkodliwych substancji z
Czytaj więcej...Wentylacja to kluczowy element każdego budynku, zapewniający odpowiednią cyrkulację powietrza i usuwanie zanieczyszczeń. Niestety, systemy wentylacyjne mogą stać się siedliskiem kurzu, pleśni, bakterii oraz innych niepożądanych substancji, które mogą wpływać
Czytaj więcej...W halach spawalniczych, gdzie codziennie wytwarzane są opary, dym i pyły, odpowiednia wentylacja jest absolutnie kluczowa dla zapewnienia bezpiecznych warunków pracy. Czysty i sprawny system wentylacyjny nie tylko poprawia jakość
Czytaj więcej...Gastronomia
restauracje, hotele, bary, przystanie, sale bankietowe, stołówki, kantyny
Placówki medyczne
obiekty służby zdrowia, przychodnie, szpitale, przemysł farmaceutyczny
Obiekty przemysłowe
zakłady produkcyjne, lakiernie hale przemysłowe i magazynowe
Obiekty sportowe
hale sportowe, parki wodne, siłownie, baseny, pływalnie
Powierzchnie komercyjne
obiekty biurowe, uczelnie, lotniska, galerie handlowe
Obiekty pływające
promy towarowe i pasażerskie, okręty, łodzie, statki wyieczkowe